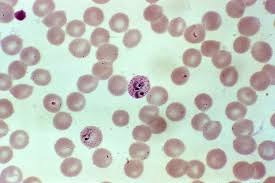

Transcription and Chromatin Structure and Function
General Director:
Roger Kornberg, Stanford University School of Medicine
Organizer:
Yossi Orly, The Hebrew University of Jerusalem
This school will cover both the historical evolution of the field of gene regulation, and the most current and updated information on the regulation of transcription in eukaryotic cell and animal models. Topics will cover descriptions of the mega complex of RNA polymerase and its accessory proteins, the activators and co-activators of transcription, the structure/function/regulations of chromatin organization and the outcome consequences on gene regulation during development and differentiation in health and diseased states.